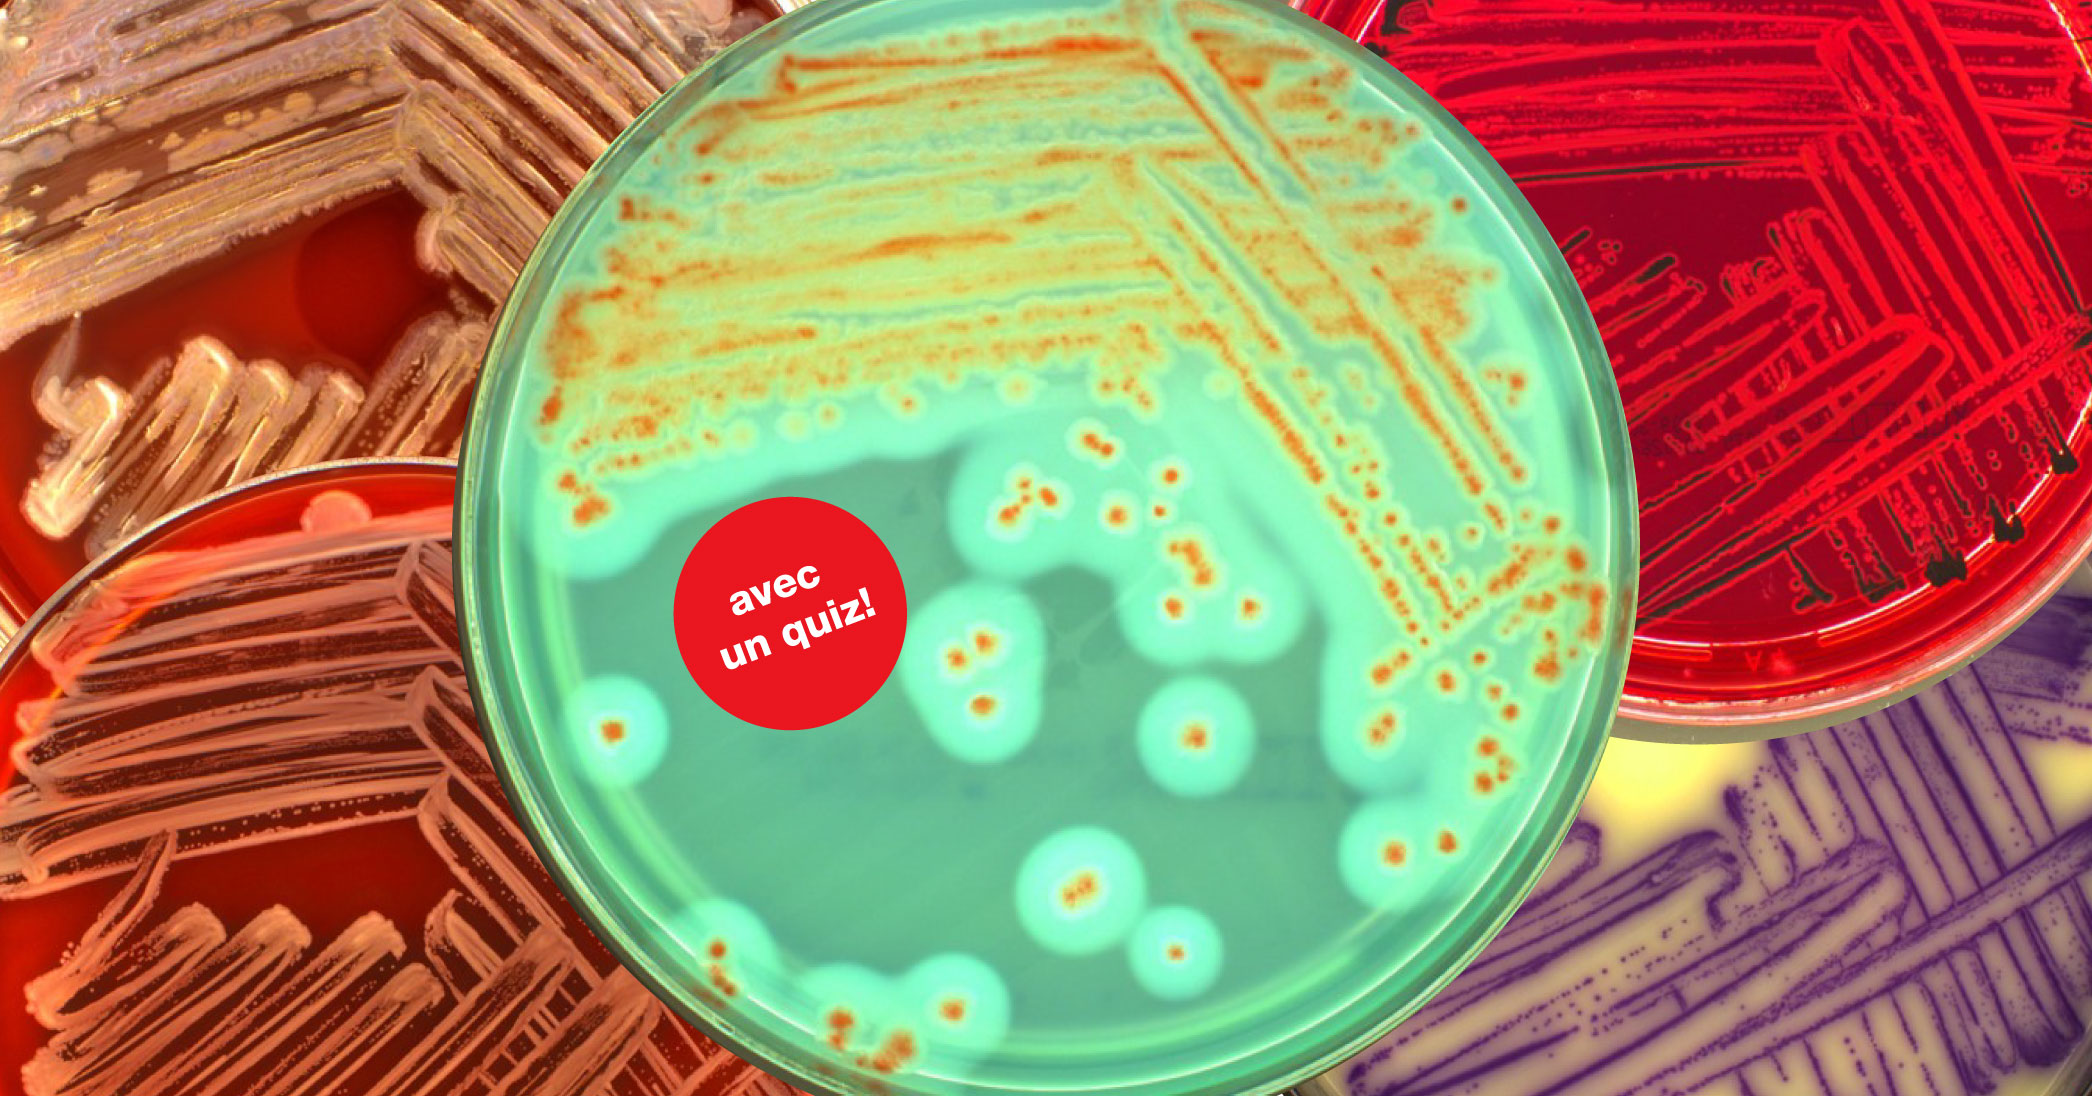

Le Laboratoire cantonal 2025
Otmar Deflorin, chimiste cantonal bernois
Éditorial

Quels thèmes ont occupé le Laboratoire cantonal bernois en 2025 ? Quels sont les défis à venir ? Et : les inspectrices et inspecteurs des denrées alimentaires peuvent-ils encore sortir manger au restaurant sans inquiétude ?
Vous le saurez en regardant le message vidéo du chimiste cantonal Otmar Deflorin.
En point de mire
Petits mais costauds : les différents rôles des micro-organismes dans les denrées alimentaires
Les bactéries ne sont pas bonnes ou mauvaises en soi. Certaines bactéries sont en effet souhaitables et confèrent à un aliment sa particularité. Les risques microbiologiques augmentent en revanche avec le nombre de produits transformés, comme le montrent les études du Laboratoire cantonal. Un petit aperçu de la pratique.

Ceux qui nous aident : les micro-organismes qui jouent un rôle de fabricants
Les micro-organismes comme les bactéries ou les levures sont largement répandus dans l’environnement : ils vivent dans la terre, sur les plantes et aussi sur notre peau. Seule une infime part d’entre eux est dangereuse pour l’être humain, beaucoup étant même utiles. Notre intestin en est un bon exemple : Il est habité par un million de micro-organismes qui jouent un rôle important pour la digestion, la fabrication de vitamines et la défense contre les agents pathogènes.
Les micro-organismes ont des processus métaboliques différents de ceux des êtres humains. C’est pourquoi leurs capacités sont utilisées depuis toujours pour fabriquer ou ennoblir les aliments. Les aliments fermentés, comme le vin, le fromage ou le yoghourt, seraient inimaginables sans l’intervention active de ces petites « aides ».
Ceux qui sont indésirables : les micro-organismes qui favorisent l’altération
Les micro-organismes peuvent toutefois aussi se propager de manière incontrôlée sur et dans les aliments et les altérer. Cela arrive lorsque les aliments sont contaminés à outrance en raison d’un manque d’hygiène ou lorsqu’ils sont stockés à des températures trop élevées et pendant une période trop longue. Les aliments transformés sont particulièrement à risque car ils constituent un terreau fertile pour la croissance microbienne.
C’est pourquoi, en 2025, plus de 2700 échantillons ont été prélevés dans le cadre d'inspections menées dans les entreprises et soumis au Laboratoire cantonal à des fins d'analyse microbiologique. Plus de 800 échantillons ont dépassé les valeurs limites prévues par la législation sur les denrées alimentaires et donné lieu à un rappel à l’ordre.
Il convient de préciser deux points :
- Le prélèvement des échantillons était fondé sur les risques. L'importance du taux de rappel à l’ordre ne permet donc pas de tirer de conclusions sur la qualité moyenne des denrées alimentaires disponibles sur le marché.
- La majeure partie des manquements concernait des dépassements des valeurs indicatives en termes de microbiologie. Cela signifie que l’hygiène était certes insuffisante, mais que la santé des consommatrices et des consommateurs n’était pas mise en péril.
Dans un quotidien où la rapidité et la flexibilité gagnent en importance, l’offre de produits transformés ne cesse de croître dans le commerce de détail. Avec les délais de conservation plus longs, les risques augmentent également. C’est pourquoi, en 2025, le Laboratoire cantonal s'est aussi focalisé sur de tels produits dans les commerces et les entreprises artisanales. Il notamment analysé 30 échantillons de jambon cuit venant du commerce de détail ou de boucheries, dont un tiers affichaient un dépassement des valeurs indicatives. Les investigations ont révélé des manquements dans la chaîne d’approvisionnement et la chaîne du froid ainsi que des délais de conservation trop optimistes.

Ceux que l'on craint : les micro-organismes qui jouent un rôle d’agents pathogènes
En 2025, le Laboratoire cantonal a analysé différents produits à risque pour y détecter d’éventuels germes comme les salmonelles et les listeria. Si ces germes causent en général des symptômes désagréables mais passagers chez les personnes en bonne santé, ils constituent un danger important surtout pour les personnes vulnérables désignées par l’acronyme YOPI, c’est-à-dire les enfants (young), les personnes âgées (old), les femmes enceintes (pregnant) et les personnes immunodéprimées (immunocompromised).
La découverte de tels germes implique en général des enquêtes approfondies et des mesures radicales pour les entreprises concernées, comme le montre l’exemple suivant : dans le cadre d’une campagne transversale dans les entreprises commerciales et artisanales, on a découvert, dans un échantillon de jambon, des bactéries de type Listeria monocytogenes. L’entreprise en question a immédiatement fait l’objet d’un deuxième test où l’on a effectué d’autres analyses de denrées alimentaires et de l’environnement. Des listeria ont été retrouvés dans six des neuf échantillons. L’entreprise s’est vu imposer des obligations de nettoyage et d’analyse complètes. De plus, elle a dû effectuer, durant les mois suivants, ses propres analyses pour que ses produits soient autorisés.
Conclusion : les contrôles ciblés sont garants de sécurité et de qualité
Les analyses microbiologiques sont un outil important pour déceler le manque d’hygiène. Elles ne contribuent pas uniquement à l’amélioration de la sécurité alimentaire mais aident aussi les entreprises à optimiser leurs processus de production afin de garantir la qualité de leurs produits. Le Laboratoire cantonal joue un rôle central dans la protection des consommatrices et des consommateurs et leur permet de s’alimenter en toute sécurité.
Faits et chiffres
En 2025, les contrôleuses et contrôleurs du Laboratoire cantonal ont inspecté un total de 6659 entreprises et prélevé quelque 11 000 échantillons de denrées alimentaires, d’eau potable et d’amiante.
Astuce : en cliquant sur les légendes, vous pouvez masquer certains composants pour voir les valeurs basses.
Activités de laboratoire
Des produits d’origine animale aux jouets, en passant par les produits de boulangerie : l’année dernière, le Laboratoire cantonal a analysé 7816 échantillons soumis à la législation sur les denrées alimentaires pour évaluer leur conformité aux exigences légales.
Des manquements ont été constatés pour 1075 échantillons sur les 7816 analysés au total. Sur le graphique, les motifs de rappel à l’ordre sont représentés proportionnellement.
Le prélèvement d’échantillons pour les analyses était fondé sur les risques. C’est pourquoi la compilation ne permet pas de tirer de conclusions sur la qualité moyenne des denrées alimentaires disponibles sur le marché.
Activité d’inspection
En 2025, 6659 entreprises du domaine de l’alimentation et de l’eau potable ont été contrôlées. Dans 230 cas, une plainte pénale a été déposée (2024 : 198). Sept entreprises ont même dû fermer (contre 7 également en 2024).
Après chaque inspection, on procède à une évaluation des résultats pour qualifier le risque global de l’entreprise (selon les catégories « insignifiant », « faible », « marqué » ou « élevé »). Cette procédure permet de fixer la date de la prochaine inspection en se basant sur les risques.
Les entreprises présentant un faible risque global sont plus rarement contrôlées que celles dont le risque est considéré comme élevé.
Statistiques relatives aux échantillons et aux inspections 2025 (en allemand)
En direct du laboratoire
À la recherche d’amiante
L’amiante a souvent été utilisé dans la construction. En raison des dangers considérables qu’il représente pour la santé, son utilisation est interdite en Suisse depuis 1990. Lorsque l’on soupçonne la présence d’amiante lors d’une rénovation, il est nécessaire de faire immédiatement appel à une ou un spécialiste.
Kevin Pintarić, expert en la matière au Laboratoire cantonal, montre en images comment un échantillon d’amiante est testé et fournit des informations utiles à ce sujet.
Dans tous les travaux de construction, la maîtrise d’ouvrage est responsable de la bonne gestion des substances polluantes. Quand des travaux de construction s’annoncent, il faut vérifier la présence d’amiante (surtout si le bâtiment date d’avant 1991).
Dangereux, l’amiante doit être prélevé avec prudence (masque FFP3, lunettes de protection et gants). L’échantillon, plus grand qu’une pièce de 5 CHF et plus petit que la paume de la main, doit comprendre toutes les couches du matériau suspect. Photo: SUVA
Tous les échantillons doivent être emballés séparément dans des sacs hermétiques et leur libellé doit être précis. Ils peuvent ensuite être remis au guichet du Laboratoire cantonal ou être envoyés à ce dernier par courrier postal.
Dès que l’échantillon arrive au laboratoire, il est enregistré dans le système et examiné par une ou un spécialiste qui le classe en différentes catégories et définit les prochaines étapes de la préparation.
Kevin Pintaric travaille au Laboratoire cantonal depuis 2021. Il avait déjà de l'expérience dans le domaine de l’amiante. Il est fier que son travail contribue à un environnement sans polluants.
Afin de protéger le personnel du laboratoire contre les fibres d’amiante, tous les travaux portant sur les échantillons ont lieu sous des hottes de laboratoire où l’air évacué est filtré.
Informations utiles concernant l’amiante
En quoi consiste exactement l’amiante ?
On entend par amiante divers minéraux d’origine naturelle à croissance fibreuse.
Pourquoi l’amiante était-il tellement apprécié ?
En raison de sa grande résistance à la flexion et à la traction, de sa grande résistance thermique, de sa résistance chimique et de ses propriétés isolantes, l’amiante a été longtemps considéré comme l’additif idéal pour les matériaux de construction. De plus, les fibres d’amiante se mélangent bien au ciment ou au plastique. C’est pourquoi de nombreux matériaux contenant de l’amiante ont été utilisés dans la construction jusqu’à son interdiction en 1990. On peut citer notamment les plaques de fibrociment, les colles de carrelage, le mastic pour fenêtres, les revêtements de sol, les isolants, les joints et les enduits.
Pourquoi l’utilisation de l'amiante a-t-elle été interdite en Suisse ?
Les fibres d’amiante peuvent avoir des conséquences fatales si elles sont inhalées. Les maladies qui en résultent ne surviennent souvent que des décennies plus tard.
Quand l’amiante est-il dangereux ?
On trouve de l’amiante dans de nombreux bâtiments ; il est la plupart du temps inoffensif pour autant qu’aucune intervention n’ait lieu. L’amiante devient dangereux surtout lorsque des travaux de transformation, de rénovation ou de démolition sont entrepris, et que les fibres libérées à ce moment-là sont inhalées. Les personnes travaillant dans les domaines de la construction et de l’artisanat sont particulièrement exposées.
Quand faut-il envoyer les échantillons au laboratoire ?
Les bâtiments et installations construits avant 1990 peuvent contenir de l’amiante. C’est pourquoi il faut analyser et retirer si nécessaire tout matériau suspect avant d’intervenir sur les bâtiments. Pour procéder aux analyses, le Forum Amiante Suisse recommande des laboratoires comme le nôtre. Ce dernier analyse chaque année environ 2000 échantillons quant à la présence d’amiante.
Informations détaillées au sujet de l’amiante :
Quiz : testez vos connaissances au sujet des laboratoires
Quel est l’aliment qui se détériore le plus vite ? Quelle utilisation étrange de l’amiante
faisait-on au 20e siècle ?
Portrait

Le Laboratoire cantonal est un office rattaché à la Direction de l’économie, de l’énergie et de l’environnement (DEEE) qui compte environ 70 collaboratrices et collaborateurs.
Il est responsable des contrôles effectués sur les denrées alimentaires, dans les entreprises du secteur alimentaire, sur les objets usuels tels que la vaisselle, les produits cosmétiques et les jouets, ainsi que du contrôle de l’eau de baignade et de l’eau potable. Il surveille également le respect des législations sur les denrées alimentaires, l’agriculture, la protection de l’environnement, les produits chimiques et la radioprotection en pratiquant des contrôles ponctuels ciblés.
Informations
Vous en découvrirez davantage sur les résultats d’analyse détaillés à la lecture des documents suivants (en allemand).